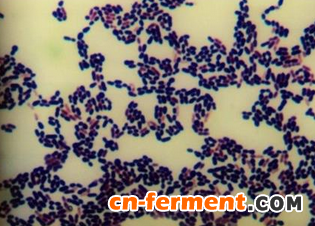
第三军医大学乳酸乳球菌获得大奖

最近,第三军医大学乳酸乳球菌获得大奖,这是学生们反复设计和改造的结果。
第三军医大学乳酸乳球菌获得大奖
近日,国际遗传工程机器大赛在美国波士顿拉开帷幕。这场合成生物学领域的顶级国际赛事,吸引了全球五大洲30多个国家和地区的283支队伍参赛。经过5天的比赛,一株小小的蓝色乳酸乳球菌摘得大赛金奖。这个通用工程菌株由第三军医大学21名本科生组成的研发团队加工而成。评审专家表示,这是一种有望加快合成生物学研发效率的优秀底盘生物。
瞄准更安全的底盘生物
合成生物学是综合利用化学、物理、分子生物学、信息学的知识和技术,设计、改造或重建生物分子、生物体部件、生物反应系统、代谢途径和过程,乃至细胞和生物个体的生物科学分支。简而言之,就是“可以像组装机器一样组配生物”。
作为一门新兴的交叉学科,合成生物学与人工智能、量子科技等并列为21世纪的颠覆性技术,在疫苗生产、药物研发、可再生能源生产、环境污染生物治理、以生物学为基础的工业制造等多个领域具有极好的应用前景。
“底盘生物是合成生物学中的重要元素之一。”第三军医大学参赛代表队总负责人、第三军医大学基础部微生物学教研室主任饶贤才介绍,“我们把一种活的生命体或细胞命名为底盘生物,将其他生物工程系统植入到底盘生物上,研发出新性能生物。打个比方,底盘生物就像汽车的车架,根据车架可以安装不同系统和零部件,制造不同品牌的汽车。”
常用的底盘生物包括大肠杆菌、枯草芽胞杆菌、酵母菌等。而细菌中使用最广泛的底盘生物大肠杆菌,在药物载体、疫苗研发等方面均存在一定的安全局限性。“为寻找更安全的底盘生物,我们将目光投向了乳酸菌。”参赛队指导老师、第三军医大学微生物学教研室胡启文副教授介绍,乳酸乳球菌是基础研究领域非常有积累的一种工程菌,长期应用在奶酪和黄油的发酵生产中。近年来,多国科学家尝试利用乳酸乳球菌作为新型药物、疫苗的载体。基因组测序结果分析表明,乳酸乳球菌基因组中不含编码毒素等损害人类健康的基因。美国食药监局已将其设定为安全共识微生物。重组表达白介素-10的基因工程乳酸乳球菌是第一个被美国食药监局批准用于临床试验的细菌,而且Ⅰ期临床试验结果再次证明了乳酸乳球菌的安全性。
从“万里挑一”到“所见即所得”
从2016年3月开始,第三军医大学参赛队员对乳酸乳球菌进行了巧妙的基因工程设计和改造,经过长达8个月的集体攻关,最终“加工”出一株蓝色的通用工程菌和一套基因工程工具包,为科研提供了一种高效的基因组快速整合筛选系统。
“过去在底盘生物上植入其他基因工程零部件或系统,由于生物学客观规律的限制,是否成功要一个一个检验。一般情况下,在一万个菌株中,只有几个或十几个能成功,真可谓万里挑一。”第三军医大学参赛队队长黄志刚兴奋地说,“而我们加工出的乳酸乳球菌,在适当培养基上呈蓝色,使用工具包植入其他有用的基因工程零部件或系统后,如果成功则会显示为白色。这种差别一目了然,高效且无任何抗生素耐药基因残留。”
“这是合成生物学领域重要的基础性改进,大量生物工程零部件及系统今后有望加载到乳酸乳球菌上,尤其在药物载体、疫苗递送等方面具有极大应有前景。同时,我们的成功经验也为其他底盘生物的优化提供了借鉴思路。”参赛队领队、第三军医大学微生物学教研室副主任胡晓梅教授说,目前,对底盘生物的改造主要有两种策略:一是使其加载更多的“东西”,另一种是植入某些元素让其运行更加高效。该研究的成功,丰富了第二种思路的实现路径。
期待美味与健康兼得
参赛队指导老师王竞博士告诉记者,队员们还对优化的乳酸乳球菌引入了食品级筛选标记抗性基因,增加了乳酸乳球菌对食品级筛选剂抗菌肽的耐受性,能够进一步增加具有生物治疗等功能的蛋白、多肽及多糖等的产量。同时,通过引导肽、锚定蛋白等融合设计,优化这些治疗性蛋白及多肽的空间定位,将乳酸乳球菌进一步升级。
“最近,我们在升级版的乳酸乳球菌上加载了临床上治疗骨质疏松的多肽药物降钙素,在另一个设计中,我们加载了一种肠道致病菌伤寒沙门菌的Vi抗原,已经成功得到这两种‘强强联合’的基因工程菌株。”黄志刚说,下一步,团队将利用动物模型,通过直接给实验动物饲喂基因工程菌株或其发酵产物如奶酪、黄油、酸奶等,检验它们在治疗骨质疏松、预防伤寒沙门菌感染中是否能达到预期效果。
“我们期待,未来可以通过喝下一杯基因工程酸奶,或吃下一块基因工程奶酪,就能达到治疗慢性疾病、预防传染病等目的,让美味与健康兼得。”胡启文憧憬道。













